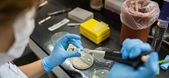

08 May, 2026
GK Update
Tue 14 Oct, 2025
National News
Employee Enrolment Scheme 2025

- The Central Government has launched the Employee Enrolment Scheme 2025 with the objective of expanding social security coverage for employees.
- This scheme will remain operational from November 1, 2025, to April 30, 2026.
- The aim of the scheme is to encourage both already registered and newly registered employers under the Employees’ Provident Funds and Miscellaneous Provisions Act, 1952, to voluntarily declare and enroll eligible employees for social security benefits.
Inauguration of the “Fare Se Fursat” Initiative

- Civil Aviation Minister Rammohan Naidu Kinjarapu inaugurated the “Fare Se Fursat” initiative.
- The initiative aims to relieve passengers from the stress of fluctuating airfares.
- It has been launched by government-owned Alliance Air to make domestic air travel more convenient across the country.
Launch of the Vishwas Scheme

- Labour and Employment Minister Mansukh Mandaviya launched the Vishwas Scheme during the 238th meeting of the Central Board of Trustees of Employees’ Provident Fund in New Delhi.
- The scheme aims to rationalize punitive compensation under the Employees’ Provident Funds and Miscellaneous Provisions Act to reduce litigation.
Key Details:
|
State News
Launch of the "CM Flight" Scheme

- The Assam Government has launched the “CM Flight” scheme.
- The initiative aims to prepare the youth of the state for global-level competition.
- The scheme was approved during a state cabinet meeting held in Dibrugarh on July 23, 2025.
Assam: Key Facts
|
Announcement for Establishment of Disabled Rehabilitation Centers

- The Uttar Pradesh Government will set up Disabled Rehabilitation Centers at each divisional headquarters.
- This initiative aims to ensure that no differently-abled person is left out of the mainstream society.
- Currently, 37 districts have operational rehabilitation centers, 11 of which are at divisional headquarters.
Uttar Pradesh: Key Facts
|
International News
North Star 2025 in Dubai

- The North Star 2025 event is being held in Dubai from October 12 to 15, 2025 (four days).
- It is the world’s largest startup and investor conference, featuring over 2,000 startups and more than 1,200 investors.
- The event is organized by the Dubai World Trade Center (DWTC) in collaboration with the Dubai Chamber of Digital Economy.
Key Details:
|
|
11th Starship Rocket Launched

- SpaceX, Elon Musk’s space company, launched its 11th Starship rocket on October 13, 2025, from Starbase, Texas.
- NASA’s Acting Administrator Sean Duffy described this mission as a “major step toward human missions to the Moon’s South Pole.”
Three Adulterated and Toxic Cough Syrups Identified in India: WHO

- The World Health Organization (WHO) has identified three adulterated and toxic cough syrups manufactured in India, including Coldrif Cough Syrup.
- WHO has warned that these cough syrups can cause serious and potentially fatal illnesses.
Affected Cough Syrups:
| Coldrif – Shreeson Pharmaceuticals | Respifresh TR – Rednex Pharmaceuticals | Relife – Shape Pharma |
78th Session of WHO for South-East Asia

- The 78th session of the WHO Regional Committee for South-East Asia (WHO SEARO RC78) began on October 13, 2025, in Colombo, Sri Lanka.
Key Details:
|
Honors and Awards
Nobel Prize in Economics 2025

- The 2025 Nobel Prize in Economics was jointly awarded to Joel Mokyr, Philippe Aghion, and Peter Howitt for their work on innovation-driven economic growth.
Key Details:
|
Special Contribution Division:
|
Economy and Banking
Inauguration of Three National Highway Projects in Puducherry

- Union Minister for Road Transport & Highways Nitin Gadkari inaugurated and laid the foundation for three national highway projects in Puducherry, costing over ₹2,000 crore.
Key Projects:
|
India’s First Semiconductor Innovation Museum

- India’s first Semiconductor Innovation Museum was inaugurated in Hyderabad, Telangana by the Technology Chip Innovation Program (T-Chip).
Key Highlights:
|
India’s Net Direct Tax Collection for FY 2025-26

- India’s net direct tax collection for FY 2025-26 reached ₹11.89 lakh crore, marking a 6.33% increase compared to the previous year.
Key Details:
|
HSBC Pledges $1 Billion Support for Indian Startups

- HSBC has committed $1 billion (approx. ₹8,880 crore) to support Indian startups under its new “Innovation Banking Platform”. The initiative will provide startups with non-dilutive debt capital, including working capital and term loans.
Key Details:
|
India’s Retail Inflation Hits Eight-Year Low

- In September 2025, India’s retail inflation fell to 1.54%, the lowest in the last eight years and the lowest since June 2017. Compared to August 2025 (2.07%), this marks a decline of 0.53%.
Key Highlights:
|
Reports and Indexes
Global Antimicrobial Resistance Surveillance Report 2025
- The World Health Organization (WHO) has released the Global Antimicrobial Resistance (AMR) Surveillance Report 2025, providing a detailed analysis of the global spread, trends, and key threats of antibiotic resistance.
- The report assesses infections caused by 8 common bacteria affecting urinary tract, gastrointestinal system, bloodstream, and other organs, along with 22 antibiotics used for treatment.
Key Highlights:
|
Important days
World Standards Day

- World Standards Day is observed internationally on 14 October every year to honor the contributions of experts and scientists from international standardization organizations such as ISO (International Organization for Standardization), IEC (International Electrotechnical Commission), and ITU (International Telecommunication Union).
Key Details:
Observed by:
|
Person In News
Mongolian President Khurelsukh Ukhnaa visits India

- Mongolian President Khurelsukh Ukhnaa arrived in New Delhi on 13 October 2025 for a four-day visit to India.
- This is his first visit to India as President.
- During the visit, India announced a Line of Credit (LoC) worth USD 1.7 billion to Mongolia — the largest development cooperation project undertaken for the country so far.
About Mongolia:
|
|
Andry Rajoelina

- Amid nationwide protests, Madagascar’s President Andry Rajoelina fled the country.
- The protests erupted last month over water and electricity shortages.
About Madagascar:
| Capital: Antananarivo | Currency: Malagasy Ariary (MGA) | Official Languages: Malagasy and French |









